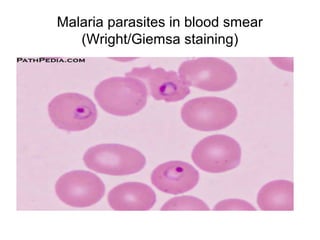
Malaria parasites in blood smear 
(Wright/Giemsa staining)

The document outlines the bacteriological diagnosis cycle, emphasizing the critical pre-analytical, analytical, and post-analytical phases. It details the importance of accurate specimen collection, labeling, and transport while highlighting specific rules to avoid contamination and ensure quality results. Additionally, it provides guidelines for microscopy and culture methods for identifying bacterial infections and testing antimicrobial sensitivity.